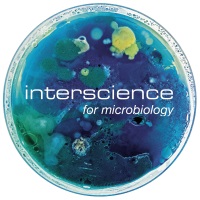

INTERSCIENCE
Exhibitor
At Interscience, we are dedicated to advancing Quality Control microbiology through innovative, reliable, and fully traceable solutions. For more than 45 years, we have been designing, manufacturing, and supplying laboratory instruments and consumables that empower food and pharmaceutical laboratories to ensure the safety, quality, and compliance of their products.
We offer a complete, end-to-end workflow, from sample preparation to bacterial enumeration and data traceability. Our portfolio includes gravimetric dilutors for precise sample dosing, high-performance laboratory blenders for homogeneous suspensions, automatic spiral platers and real-time incubators for standardized culture and analysis, and AI-powered colony counters for rapid, objective, and reproducible results. Complemented by a full line of sterile sampling and blender bags, our solutions guarantee reliability and efficiency at every stage of microbial testing.
In the food industry, our systems play a key role in Quality Control and safety assurance, supporting laboratories with:
-
Microbiological testing of food, water, and raw materials
-
Shelf-life and hygiene monitoring, ensuring consistency across production lines,
-
and digital traceability that supports audit-readiness and data integrity.
In the pharmaceutical sector, we support QC microbiology laboratories through solutions designed for:
-
Environmental Monitoring (EM) — surface and air sampling in cleanrooms and controlled environments,
-
Testing of finished products, intermediates, and raw materials — bioburden and microbial limits testing in accordance with pharmacopeial standards,
-
Sterility testing and contamination control, ensuring data integrity and traceability under GMP and 21 CFR Part 11 requirements.
Our Scan Ai and Data Link platforms bring digital intelligence to QC microbiology, enabling automated image analysis, secure data management, and full process traceability across both food and pharmaceutical applications. These systems help laboratories improve throughput, accuracy, and compliance while reducing manual intervention.
Proudly designed and manufactured in France, our instruments combine robust engineering, validated performance, and long-term reliability. With a global presence and strong network of distributors and subsidiaries, we deliver local expertise, training, and technical support to laboratories worldwide.
At Interscience, our mission is to make Quality Control microbiology faster, smarter, and more reliable — enabling food and pharmaceutical manufacturers to protect consumers, comply with regulations, and release products with complete confidence.
GET INVOLVED

